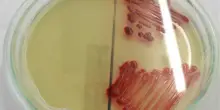
Serratia marcescens: cos'è, perché può essere pericolosa e chi è più a rischio

s

Cronaca
Serratia marcescens, come arriva in ospedale il batterio killer: sintomi e cure
14-08-2025, 15:41
Molto diffuso nell’ambiente, può causare infezioni nell'uomo, spesso legate all’ambiente ospedaliero. Può risultare fatale in persone con sistema immunitario compromesso
CONTINUA A LEGGERE

25

0

0
Guarda anche
Quotidiano.net
Ieri, 22:57
Il video straziante di Fallou, "sono il figlio migliore di tutti"
Quotidiano.net
Ieri, 22:49
"Quei ragazzi con il coltello, armati di paura"
Quotidiano.net
Ieri, 21:18
Schlein a confronto coi sindaci Pd: “L’austerità di Meloni la pagate voi”
Quotidiano.net
Ieri, 21:02
Il Segretario Usa Pete Hegseth installa targa del Dipartimento della Guerra
Quotidiano.net
Ieri, 20:18

.jpg?_=1675865569)